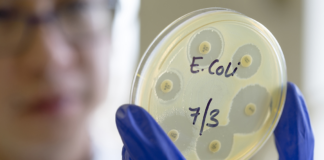
Investigan brote de E. coli con quesos que golpeó a Texas y otros tres estados Investigan brote de E. coli con quesos que golpeó a Texas y otros tres estados

Una subvención de $46 millones de los Institutos Nacionales de Salud ayudará a UT Health San Antonio a llevar la ciencia de vanguardia a las comunidades más rápidamente. El Dr. Robert Clark, director del Instituto para la Integración de la Medicina y la Ciencia en UT Health San Antonio , dijo que actualmente las personas tardan un promedio de 17 años en beneficiarse de los descubrimientos científicos.
“Queremos que ese proceso sea más rápido, más eficiente y más confiable para que no haya tanto tiempo de inactividad para poder llegar a ese punto final objetivo de un nuevo tratamiento y un diagnóstico, un nuevo enfoque para algún problema de salud pública”, dijo Clark, según la nota de Texas Public Radio. La subvención NIH de $46 millones del Centro Nacional para el Avance de las Ciencias Traslacionales apoyará los programas de ciencias traslacionales durante los próximos cinco a siete años en ocho instituciones del área. El objetivo es reducir las disparidades de salud entre los mexicoamericanos, el personal militar activo y los veteranos, según Clark.
El Instituto para la Integración de la Medicina y la Ciencia coordina la financiación, y los socios incluyen la Facultad de Medicina y Farmacia de la Universidad de Texas en Austin Dell, el Instituto de Investigación Biomédica de Texas, el Distrito de Salud Metropolitano de San Antonio, el Sistema de Salud Militar de San Antonio, el Departamento de Salud de los Veteranos del Sur de Texas Sistema de Atención y Salud Universitaria.
Esta es la cuarta vez que UT Health San Antonio ha sido seleccionado para recibir un premio multimillonario NIH Clinical and Translational Science Award desde 2008. “Eso indica que San Antonio es muy respetado a nivel nacional en términos de investigación relacionada con la salud y atención de la salud”, dijo Clark, y agregó que es un reconocimiento de los sólidos programas académicos y comunitarios de la ciudad que son líderes en la traducción de la investigación científica a la clínica y a la salud pública.